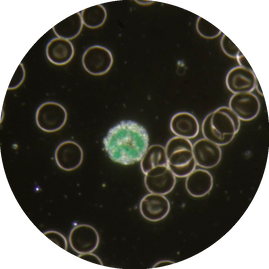

Curso Avançado de Microscopia para Análise de Parasitas em Medicina Veterinária
O Curso Avançado de Microscopia para Análise de Parasitas em Medicina Veterinária é uma formação essencial para profissionais que desejam aprofundar as suas habilidades no diagnóstico parasitário, utilizando as poderosas técnicas de microscopia de campo claro e campo escuro. Este curso é uma imersão nas nuances da parasitologia diagnóstica, focando na identificação precisa de parasitas em amostras de sangue e fezes dos nossos pacientes.
Os parasitas sanguíneos (hemoparasitas), geralmente são protozoários ou nematóides filarídeos que residem nas células sanguíneas ou no plasma. A transmissão ocorre, na maioria dos casos, por vetores artrópodes (carrapatos, pulgas, mosquitos).
Os parasitas gastrointestinais e pulmonares, são encontrados sob a forma de ovos, larvas, cistos ou oocistos nas fezes, refletindo infestações no trato gastrointestinal ou, em alguns casos, no sistema respiratório.
A grande diversidade e vasta disseminação destes parasitas traz enormes desafios ao diagnóstico clínico.
Neste contexto, o diagnóstico parasitológico preciso é um pilar fundamental na medicina veterinária preventiva e terapêutica. A capacidade de identificar corretamente parasitas, seja no sangue circulante ou nas fezes, é crucial para a implementação de tratamentos eficazes, o controlo de zoonoses e a gestão da saúde dos animais de companhia ou equinos. Este curso vai além do básico, explorando métodos avançados de concentração e coloração, bem como a aplicação da microscopia de campo escuro, uma técnica que pode revelar detalhes morfológicos e comportamentais de parasitas no seu estado vivo, complementando a visão tradicional do campo claro.
OBJECTIVOS
Este programa foi meticulosamente desenhado para aprimorar as suas competências em diagnóstico parasitológico microscópico. Ao final do curso, os nossos formandos devem:
-
Dominar Técnicas de Preparação de Amostras: Capacitar os alunos na preparação de amostras de sangue e fezes, incluindo métodos de concentração e coloração avançados, para maximizar a deteção de parasitas.
-
Aprofundar a Identificação Microscópica: Fornecer conhecimentos detalhados sobre a morfologia e ciclos de vida dos principais parasitas de interesse veterinário encontrados em amostras sanguíneas (ex: Babesia, Anaplasma, Dirofilaria) e fecais (ex: ovos e oocistos de nematóides, cestóides, trematóides e protozoários), utilizando as modalidades de campo claro e campo escuro.
-
Utilizar a Microscopia de Campo Escuro: Ensinar a aplicação da microscopia de campo escuro para a visualização de parasitas em seu estado vivo, permitindo a observação de motilidade e características que podem ser perdidas em preparações fixas.
-
Diferenciar Artefactos de Parasitas: Desenvolver a capacidade crítica de distinguir estruturas parasitárias reais de artefactos e contaminantes, evitando diagnósticos erróneos.
-
Interpretar Achados no Contexto Clínico: Habilitar os participantes a correlacionar os achados microscópicos com os sinais clínicos dos animais, otimizando o diagnóstico e a escolha do tratamento.
PERFIL DO FORMANDO
Este curso avançado é ideal para profissionais e futuros profissionais da medicina veterinária que desejam elevar o seu nível de expertise em parasitologia diagnóstica. O perfil dos alunos inclui:
-
Médicos Veterinários: Que procuram aprimorar as. suas habilidades de diagnóstico parasitológico em clínicas, hospitais, laboratórios ou no campo, para uma gestão de saúde animal mais precisa e eficaz.
-
Patologistas Clínicos Veterinários: Que desejam aprofundar técnicas avançadas de análise e interpretação de amostras parasitárias.
-
Residentes e Internos em Medicina Veterinária: Que necessitam de uma base sólida e avançada em parasitologia diagnóstica para a sua formação especializada.
-
Técnicos de Laboratório Veterinário: Com experiência prévia em análises clínicas, que pretendem especializar-se em parasitologia e dominar técnicas microscópicas avançadas.
-
Estudantes de Pós-Graduação em Medicina Veterinária: (Mestrado, Doutoramento) envolvidos em investigação ou prática clínica que exija um conhecimento aprofundado em diagnóstico parasitário.
Convidamo-lo a juntar-se a nós para aprofundar os seus conhecimentos e competências na identificação de parasitas, contribuindo significativamente para a saúde e bem-estar dos animais.

EDIÇÕES ANTERIORES
Cursos Avançado de Microscopia Campo Escuro e Claro

EDIÇÃO 2022
EDIÇÃO 2023
EDIÇÃO 2024
ORGANIZAÇÃO